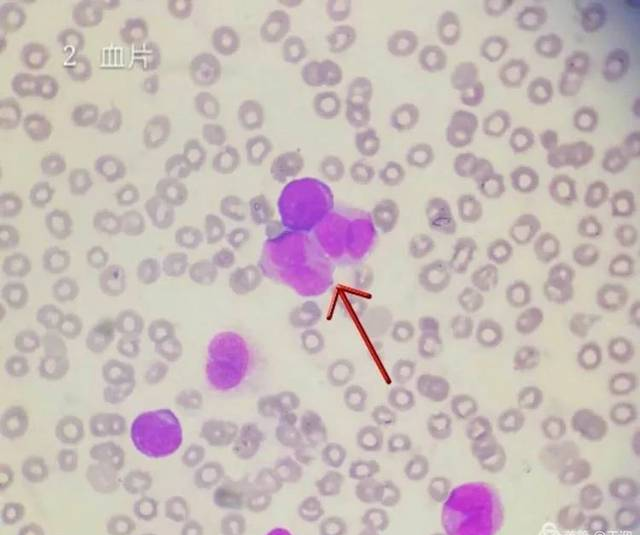

最近,一条题为《医生警告再三:吃完香蕉30分钟内,别沾它,当心“吸引”癌细胞》的视频在网上流传。视频中称,吃完香蕉半个小时内喝酸奶的话,会致病,甚至还会激活癌细胞。此...
高中生物光合作用和细胞呼吸知识点 细胞呼吸这一内容是高中生物学教学的重点和难点,下面是高三网小编给大家带来的高中生物光合作用和细胞呼吸部分知识点总结,希...
南京新百于6月6日晚间公告,就转让House of Fraser Group控股权回复交易所问询函,并宣布7日复牌,停牌四个月后,南京新百终于在市场的关注下迎来了复牌。 5月23日,南...
初一上生物细胞核是遗传信息库知识点 一、遗传信息的定义:上一代能把控制生长发育的信息传给下一代,这样的信息就叫做遗传信息。 二、遗传信息储存在细胞核中...
报道指出,图片上看得到太阳表面布满细胞样结构。每一个太阳表面的细胞样结构相当于一个得克萨斯州的面积。 这些细胞样结构则是太阳剧烈运动的标志。太阳表面翻...
现在癌症的患者是越来越多了,癌症患者去世以后,肿瘤细胞是不是也会死亡呢?但是肯定的,人死了之后,肿瘤细胞也会死亡的。肿瘤细胞从本质上来说就是一个变异的细胞,他虽然...